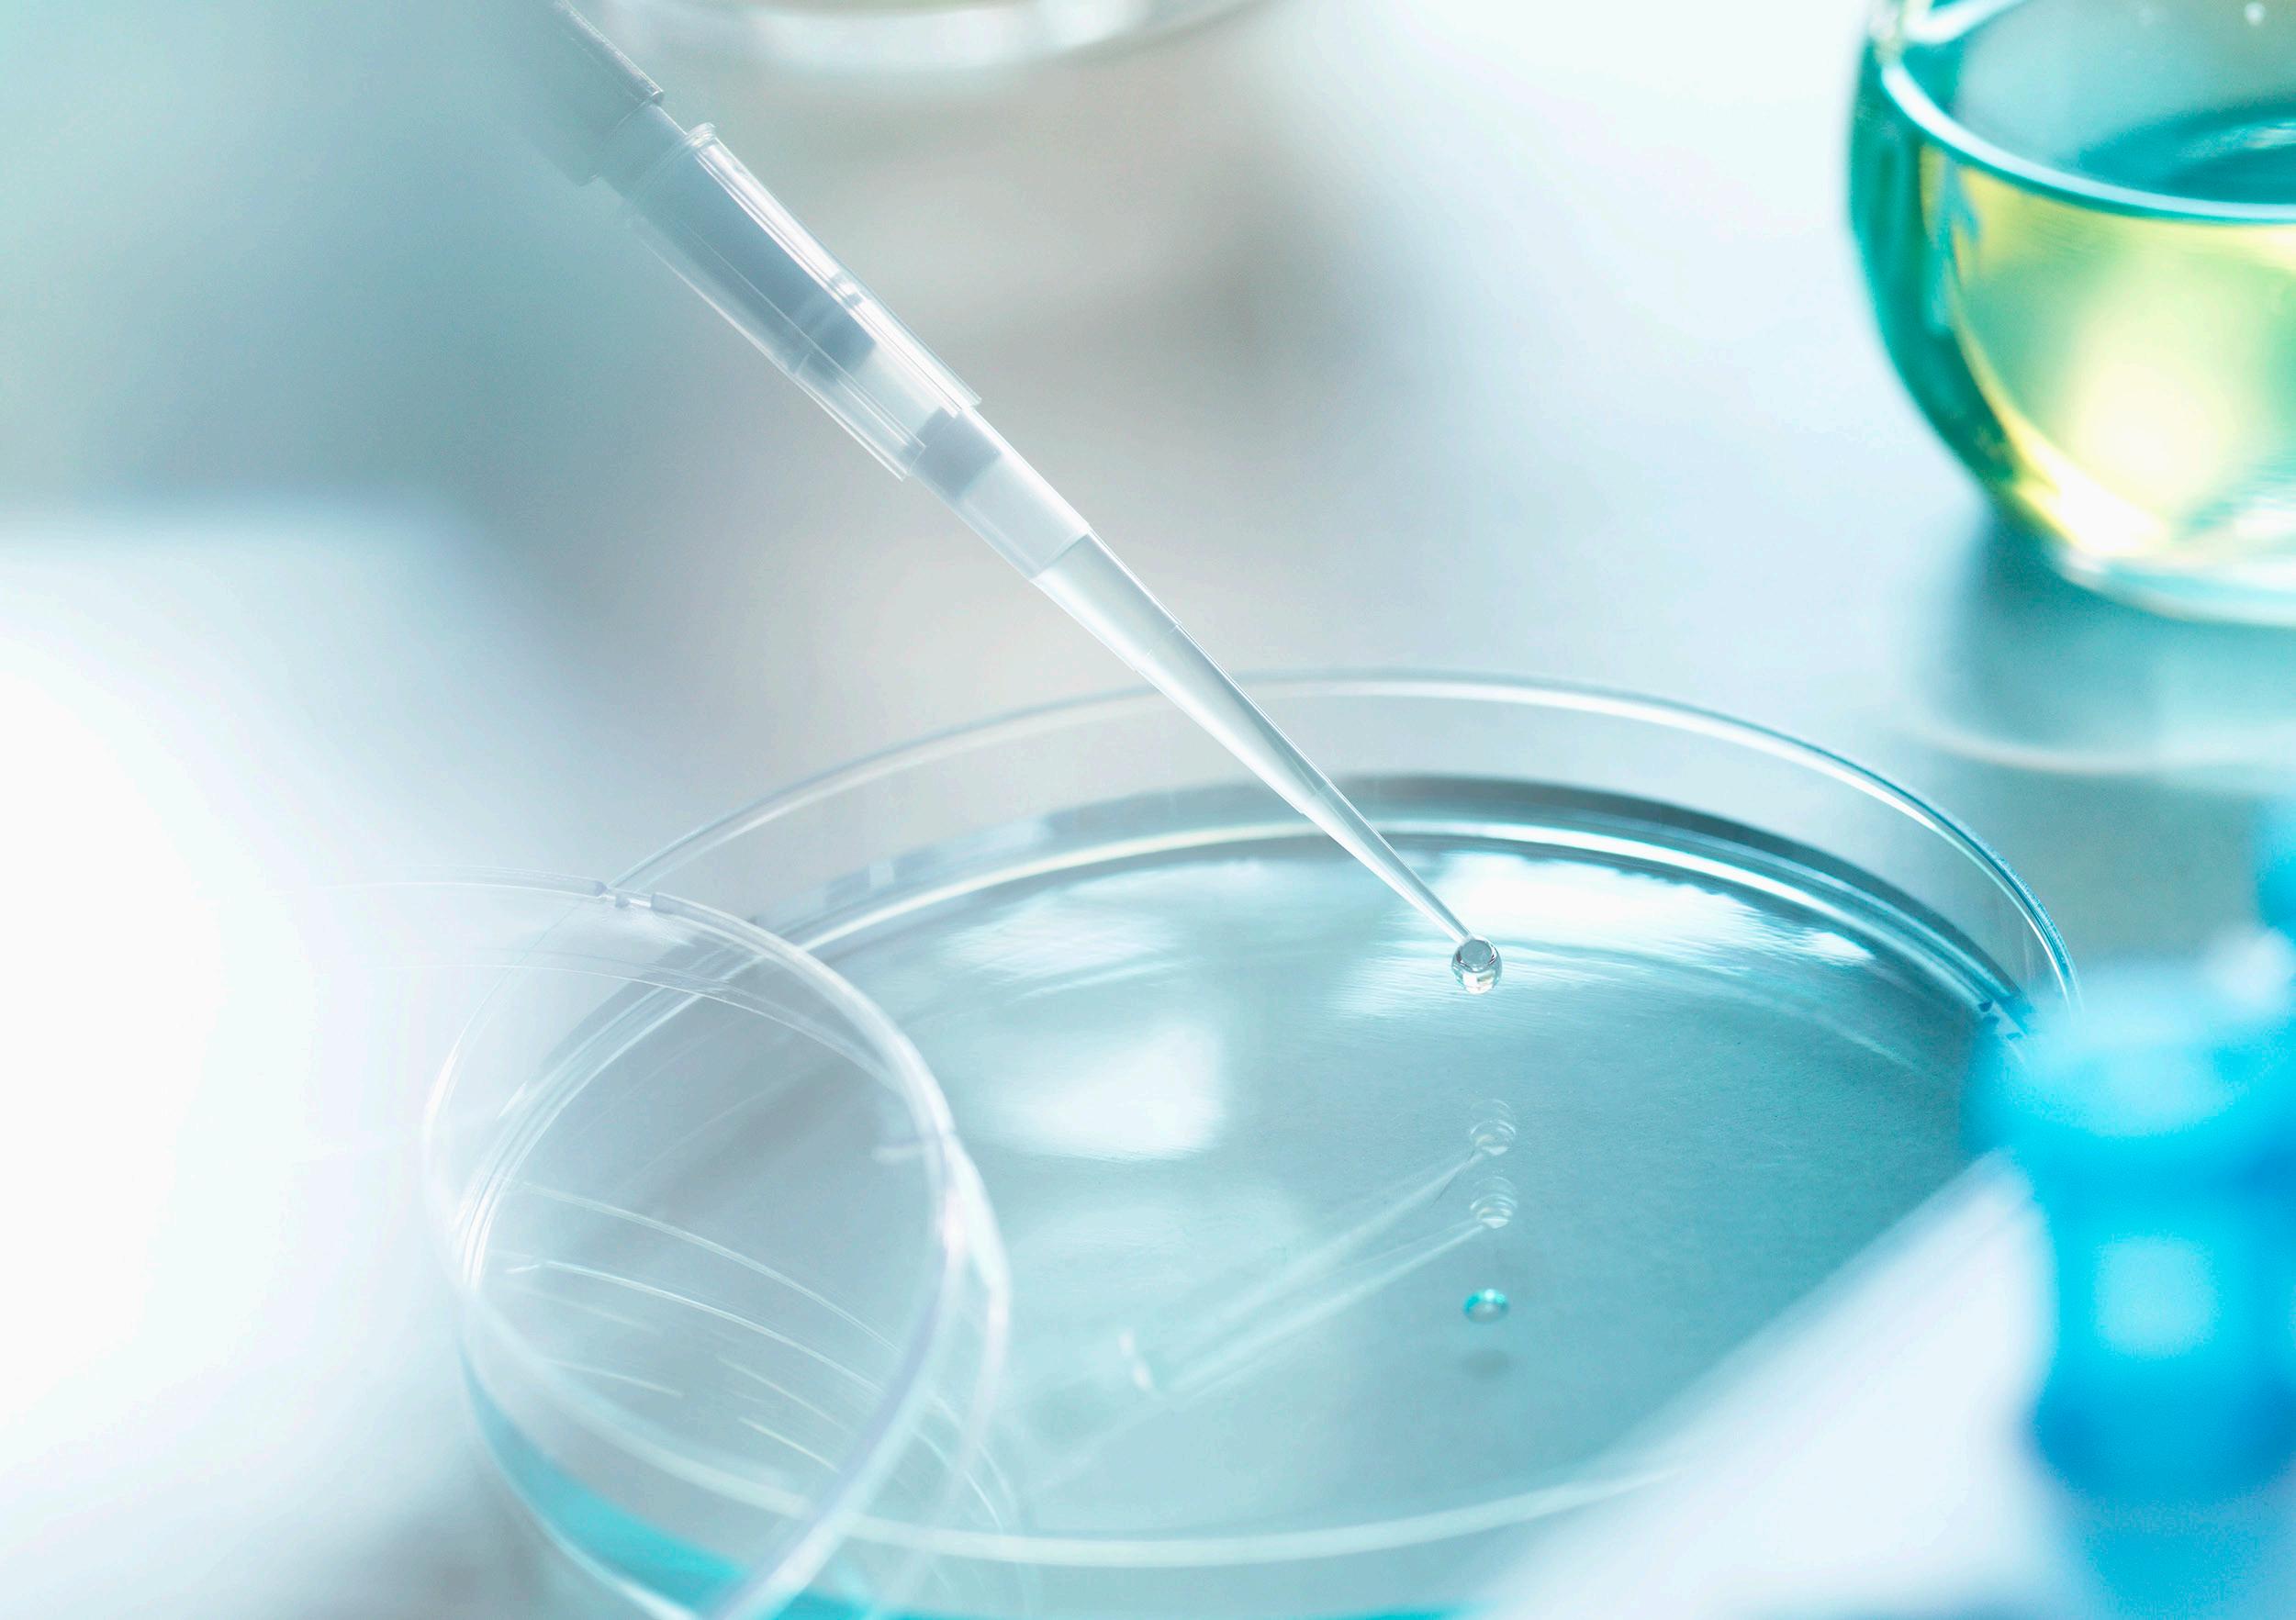

Het woord “zinzino” betekent iets kleins van grote waarde.
Voor ons bent u oneindig waardevol.
Daarom zijn we op een missie om uit elk van ons het allerbeste te halen .
Inspire Change in Life
De weg naar een betere gezondheid is een persoonlijke reis. Gissen hoort er niet bij.
U bent uniek.
Onze reis begint met onze gezondheidstesten.
Zo brengen wij u en de wereld weer in balans.
“Wij zijn de pioniers op het gebied van op testen gebaseerde, persoonlijke voeding uit het land van het noorderlicht, middernachtzon plus de diepste fjorden en de steilste bergen.”
Laat het duister achter u.
Sluit u aan bij de nieuwe norm voor persoonlijke gezondheid.
Doe uw eerste test als nulmeting voordat u begint aan uw op maat gemaakte routine van supplementen. Doe uw volgende test om uw vooruitgang te volgen en concreet bewijs op schrift te krijgen dat de producten verschil maken.
Gesteund door onze Wetenschappelijke Advies Raad,
onze eigen onderzoeks- en ontwikkelingsspecialisten
Een met zorg geselecteerde groep van artsen, onderzoekers en vooraanstaande gezondheidsdeskundigen van over de hele wereld.
…en de wereldleider op het gebied van bloedvlektesten
Vitas, is een onafhankelijk beheerd, GMP-gecertificeerd contractlaboratorium voor chemische analyse in Oslo, Noorwegen.
Dr. Paul Clayton
Dr. Anantharaj Abraham
Dr. Angela M. Rizzo
Dr. Natalie Kather
Ola Eide
Stephen Cherniske
Dr. Martina Torrissen
Dr. Emmalee Gisslevik
Dr. Colin Robertson
Kennis is macht. En gemoedsrust.
Uw reis richting bewustzijn begint met één druppel bloed.
Wist u dat één enkele druppel bloed meer moleculen bevat dan alle zandkorrels in de Sahara?
Onze droge bloedvlektest geeft u de harde feiten over uw huidige gezondheidsstatus en welke voedingsstoffen uw lichaam ontbeert.
Ondersteund door de wetenschap.
Aangedreven door de natuur.
Testen, niet gissen.
Zinzino ontsluit het geheim van een uitgebalanceerd leven.
Onze formule is een heuse natuurkracht en olijfolie is de game-changer.
Daarom lijkt
BalanceOil+
meer op vette vis dan visolie.
Door pure visolie te combineren met extra vergine olijfolie van voortijdig geoogste olijven blijven de Omega-3
voedingsstoffen vers en krachtig, samen met de krachtige antioxidanten die van nature te vinden zijn in vis.
Onze gezondheidstesten onthullen welke voedingsstoffen
uw lichaam nodig heeft.
Het Gezondheidsprotocol toont u de weg voorwaarts.
1. Evenwicht
2. Herstel
3. Ondersteuning
Krijg al uw essentiële voedingsstoffen met onze top drie op maat gemaakte supplementen die in synergie werken.
Op natuurlijke wijze ontwikkelde oplossingen om uw hele lichaam te voeden. Van binnen en van buiten.
Ons holistische gezondheidsen welzijnsaanbod is ongeëvenaardvan voedingssupplementen tot biotech huidvoedingsstoffen.
Breng uw essentiële
Omega-6:3 niveaus in balans.
ONS BESTVERKOCHTE DARMFLORA SUPPLEMENT
Herstel de gezondheid van uw darmen.
Ondersteun uw eerste verdedigingslinie.
ONZE GEAVANCEERDE VOEDING VOOR DE HUID
Voed uw huid van binnenuit.
Leer de volgende generatie
Omega-supplementen kennen.
Ons assortiment supplementen Omega Balance voedingssupplementen met polyfenolen is bepaald door ons Scandinavisch erfgoed, een Noorse formule en hoogwaardige, met zorg verkregen, natuurlijke ingrediënten.
Een kleine BalanceShot.
Een grote stap voor de menselijke gezondheid.
Geteste,
persoonlijke voeding in de praktijk gebracht.
Onze wetenschappelijke gezondheidstesten onthullen unieke inzichten over uw lichaam.
Onze gepersonaliseerde voedingssupplementen helpen u om elk onderdeel ervan te beheersen.
GEZONDHEID VAN DE DARMEN
GEWICHTSBEHEERSING
Wij verzorgen u.
Letterlijk.
Voeg vegan, biotech voedingsstoffen voor uw huid toe aan uw dagelijkse routine van supplementen en houd u huid even gezond en in balans als van binnen.
Neem
een abonnement op een beter leven.
Gezonder leven is niet zo even gedaan. Een abonnement biedt onze supplementen de tijd om te werken. Maandelijkse leveringen thuis helpen onze planeet.
Onze partners begeleiden u de hele weg.
Een persoonlijke welzijnsconsulent is altijd onderdeel van uw abonnement. Iemand die uw voortgang bijhoudt en u op het goede spoor houdt totdat u uw gezondheidsdoelen bereikt.
Op een leven in balans.
From the pioneers of test-based, personalized nutrition.
Get social with us!
#ZinzinoOfficial
Zinzino Operations AB
Hulda Mellgrens gata 5, SE-421 32 Västra Frölunda, Zweden zinzino.com